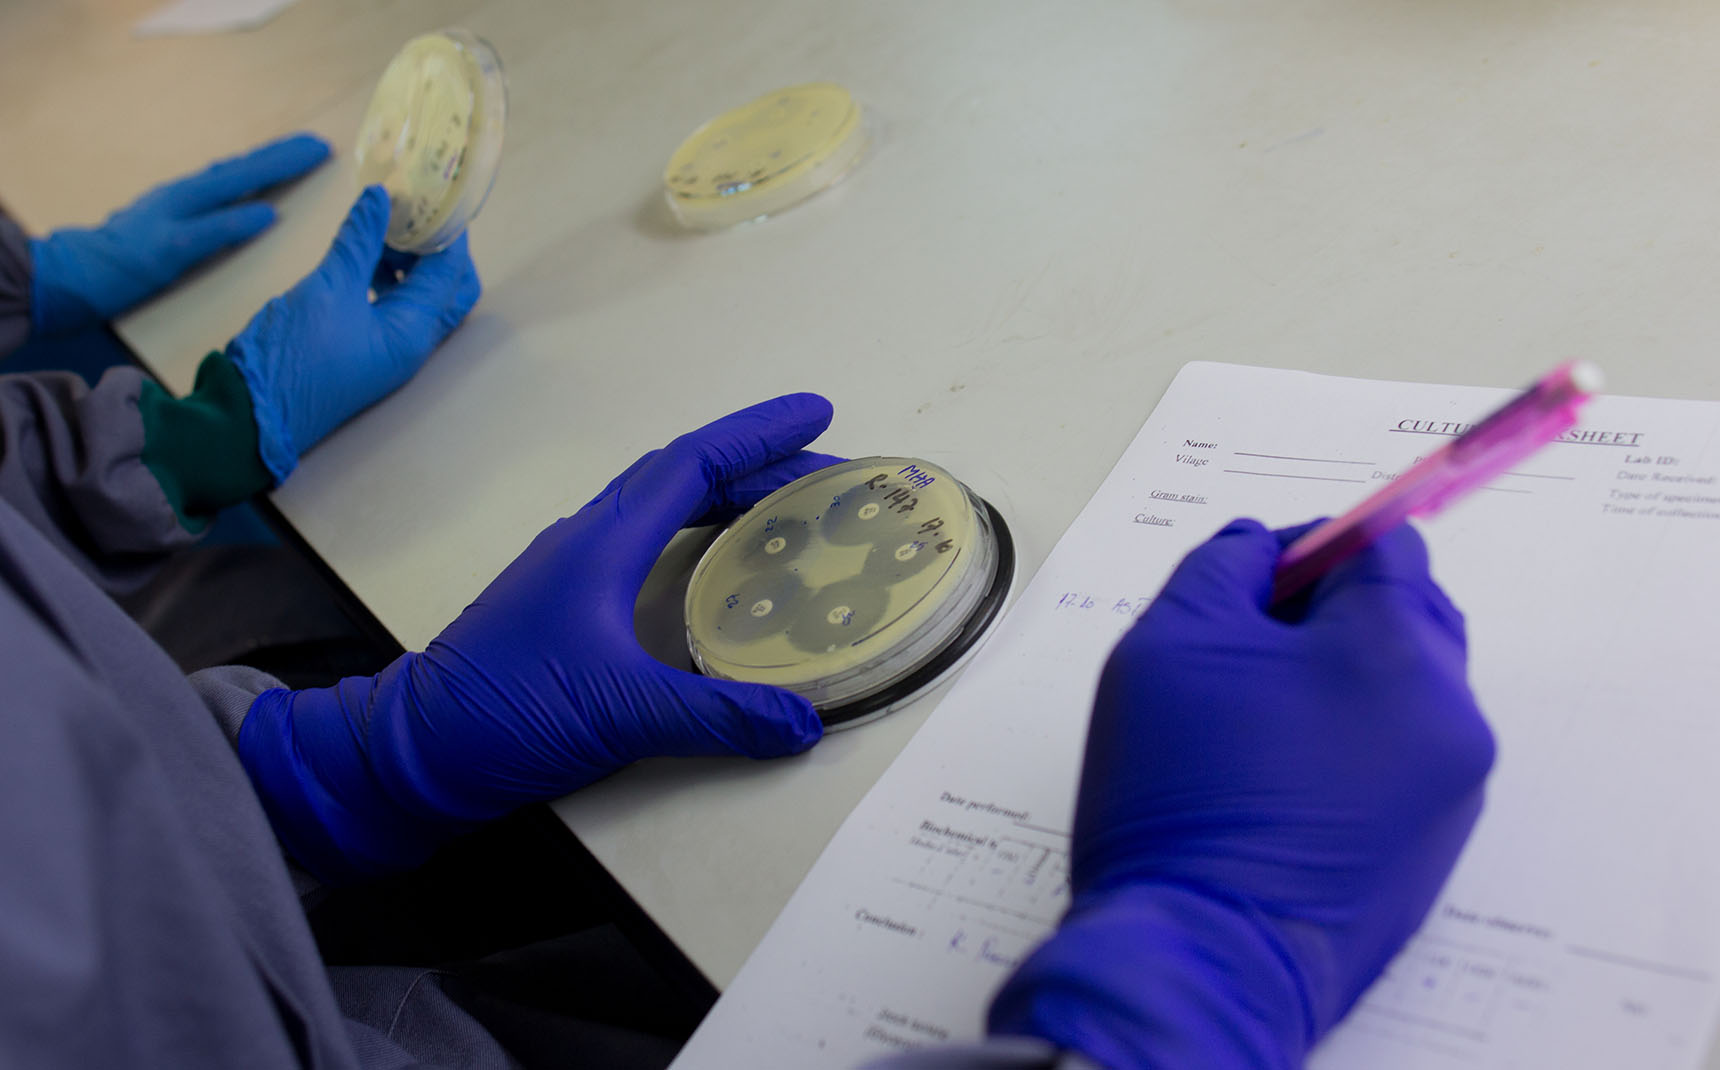
Deux mains gantés bleues manipulent une boîte de pétri.

Nos priorités
La Fondation Mérieux intervient à l’international contre les maladies infectieuses les plus meurtrières, telles que la tuberculose et les infections respiratoires aiguës. Elle fait de la lutte contre la résistance aux antimicrobiens une priorité, et se mobilise également sur les pathogènes émergents et réémergents.
SARS-CoV-2, choléra, Ebola, Zika, lèpre… Certains pathogènes affectent soudainement les populations, qu’ils aient déjà été identifiés par la communauté scientifique (pathogènes réémergents) ou non (pathogènes émergents).
Depuis 50 ans, les épidémies liées à ces maladies se font de plus en plus fréquentes, aidées par des facteurs environnementaux et sociaux comme la crise climatique ou les déplacements de populations.
Lors de l’émergence ou de la réémergence de ces pathogènes, les pays à revenu faible et intermédiaire sont particulièrement exposés.

La recherche est essentielle pour lutter contre les pathogènes émergents. C’est pourquoi la Fondation Mérieux développe régulièrement des programmes de recherche sur des pathogènes spécifiques, y compris sur leur épidémiologie. Les réseaux internationaux de laboratoires qu’elle accompagne et ses partenaires de toutes disciplines sont mobilisables rapidement en cas d’émergence ou de réémergence d’un pathogène dangereux.
En déployant des projets de renforcement des systèmes de laboratoires de biologie médicale, la Fondation Mérieux soutient également les pays les plus exposés dans leurs capacités de diagnostic. Elle appuie la surveillance de l’évolution des épidémies aux niveaux national et régional par les autorités. Ce faisant, elle les aide à formuler des réponses adaptées en cas d’émergence ou de réémergence d’un pathogène.
Parce que 75 % des maladies émergentes ont une origine animale et que les pathogènes ne connaissent pas de frontières, la Fondation Mérieux adopte une approche One Health (« Une seule santé ») qui considère ensemble la santé humaine, animale et les enjeux environnementaux. Cette approche s’avère essentielle pour lutter efficacement contre les pathogènes émergents et réémergents, car elle permet de mieux comprendre leur origine et leurs modes de propagation.
des maladies infectieuses émergentes ont une origine animale